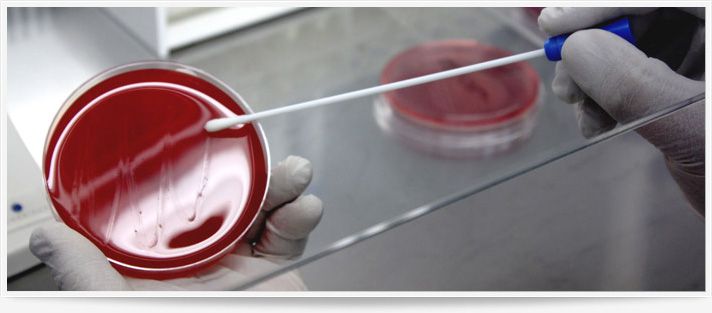

Esenzioni Esami
Scopri se hai diritto all’esenzione e come usufruirne per gli esami di laboratorio.
Esenzioni dal pagamento del ticket sanitario
Il Servizio Sanitario Nazionale prevede l’esenzione dal pagamento del ticket per alcune categorie di cittadini e per specifiche condizioni cliniche. Presso il nostro laboratorio puoi usufruire dell’esenzione, presentando la documentazione necessaria al momento dell’accettazione.
Troverai indicazioni su:
- Particolari situazioni di reddito, spesso associate all’età o alla condizione sociale;
- Presenza di determinate patologie croniche;
- Presenza di patologie rare riconosciute;
- Riconoscimento dello stato di invalidità;
- altri casi specifici, come gravidanza, programmi di diagnosi precoce di alcune malattie o accertamenti sanitari mirati.
Per ogni dubbio o verifica sulla tua posizione, il nostro personale è a tua disposizione per assisterti e aiutarti a compilare correttamente la richiesta.
TABELLA TICKET
| CATEGORIA | CODICE | QUOTA RICETTA |
|---|---|---|
| Esenti Totali | E02-E03-E04 F01-G01-G02 V01-V02 023 | €0 |
| Reddito | E01 | €5 |
| Patologia | Relativo alla Patologia | €5 |
| Reddito (Parziale) | E05 | €10 (solo ticket NAZIONALE) |
| Non Esenti | €20 (ticket NAZIONALE + ticket REGIONALE) |

ESENZIONE PER REDDITO
L’appartenenza a un nucleo familiare con un reddito inferiore ai limiti previsti dalla normativa consente l’accesso all’esenzione solo se associata a determinate condizioni personali o sociali, come l’età (minori o anziani) o particolari situazioni lavorative e previdenziali. La verifica del diritto all’esenzione e della fascia economica di appartenenza avviene generalmente al momento della prescrizione della prestazione sanitaria. Il medico, sulla base delle informazioni disponibili nei sistemi informativi sanitari, indica l’eventuale esenzione direttamente sulla ricetta.
I dati relativi al reddito familiare derivano dalle dichiarazioni fiscali e vengono periodicamente aggiornati. I medici abilitati possono consultare tali informazioni e confermare o meno il diritto all’esenzione su richiesta dell’assistito. Nel caso in cui il cittadino non risulti presente nei sistemi informativi o ritenga che la propria situazione economica non sia correttamente rappresentata, è necessario rivolgersi agli uffici competenti per effettuare le opportune verifiche o presentare un’autodichiarazione.
È fondamentale compilare l’autodichiarazione con attenzione e correttezza: l’utilizzo improprio di un’esenzione non spettante comporta il recupero delle somme dovute e può dar luogo a conseguenze di natura amministrativa o penale. Qualora le condizioni di reddito cambino, è obbligatorio comunicarlo tempestivamente agli uffici preposti.
Alcune tipologie di esenzione, in presenza di determinati requisiti anagrafici ed economici, possono avere validità illimitata, purché la situazione economica e patrimoniale rimanga invariata.
ESENZIONE PER MALATTIE CRONICHE
Per alcune malattie croniche è prevista la possibilità di accedere in esenzione dal pagamento del ticket a determinate prestazioni sanitarie di specialistica ambulatoriale. Tali prestazioni sono finalizzate principalmente al monitoraggio della patologia, al controllo della sua evoluzione e alla prevenzione di complicanze o aggravamenti.
Le patologie che danno diritto all’esenzione sono individuate all’interno di specifici elenchi aggiornati periodicamente. Per ciascuna malattia vengono generalmente definiti insiemi di prestazioni sanitarie considerate appropriate ed efficaci per la gestione della condizione clinica. Il medico valuta, caso per caso, quali prestazioni prescrivere in base allo stato di salute e alle esigenze assistenziali del paziente.
Non rientrano nell’esenzione le prestazioni sanitarie necessarie alla fase di diagnosi della malattia, che restano soggette alle regole ordinarie di partecipazione alla spesa.
Per ottenere l’esenzione è necessario presentare una certificazione sanitaria che attesti la presenza della patologia cronica riconosciuta. La documentazione può provenire da diverse strutture sanitarie e viene valutata dagli uffici competenti. A seguito della verifica, viene rilasciato un attestato di esenzione che riporta la patologia o condizione riconosciuta, il relativo codice identificativo e l’elenco delle prestazioni fruibili senza pagamento del ticket.
esenzione per malattie rare
Le malattie rare che danno diritto all’esenzione dal pagamento del ticket sono individuate sulla base di criteri generali quali la bassa diffusione nella popolazione, la gravità clinica, l’impatto invalidante e l’elevato costo delle cure e dei trattamenti necessari. L’elenco delle malattie rare riconosciute è oggetto di aggiornamenti periodici. L’esenzione copre tutte le prestazioni sanitarie considerate appropriate ed efficaci per il trattamento, il controllo e il monitoraggio della patologia rara accertata, nonché per la prevenzione di eventuali aggravamenti.
A differenza di quanto previsto per le malattie croniche, per le malattie rare possono essere incluse in esenzione anche alcune prestazioni diagnostiche, soprattutto quando il percorso di accertamento risulta complesso, lungo o particolarmente oneroso. Rientrano inoltre tra le prestazioni esenti alcune indagini genetiche effettuate sui familiari, qualora risultino necessarie per confermare la diagnosi di una patologia rara di origine genetica.
Prenota, previeni, prenditi cura di te
Scegli il Laboratorio Schiavo e il Centro Antidiabete per un’assistenza completa, affidabile e su misura.





